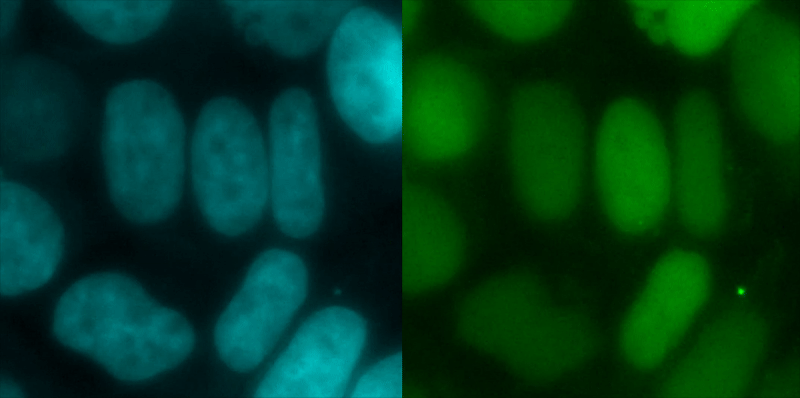

Assays!
The best part of my undergrad research - colourimetric assays



These were all measuring conversion of carbohydrates by our bacteria, if I remember correctly. I havent gotten to do any assays like this since, which sucks!!
I guess I'm onto more advanced techniques now, which means machines get to see the colours instead of me :(
Microscopy
Click to open pictures in a new tab
My pictures
On our first day in the microscopy lab, we finished early and had a bit of extra time so our supervisor suggested we play with the lasers. We decided to vandalise some cells by bleaching them (i.e. destroy the fluorescent molecule on them), and emblasoned them with a '2', since we were group 2.


What am I looking at?
IIRC, these are endothelial cells. The picture on the right is a composite of the three in the left-most picture, overlaid together. These cells have been 'dyed' with three different fluorphores. The blue (DAPI) has stained the nucleus, the green has stained the actin (the scaffolding of the cell), and the red has stained the mitochondria.
FLIM experiments:
These are from a mini-experiment we ran as part of our course work. The fluorescent areas are the activation of calcium sensors, where brighter = increased calcium in that area of the cell.
Want more details?
We used a mScarlet based sensor to track calcium dynamic in the cell, using FLIM. We imaged cell responses after exposure to thapsigargin, YODA1, and histamine, but I didn't include those here because honestly they weren't as cool/dramatic.
In the images below, we used an Opto-FGFR to influence calcium rather than the drug mentioned above, which you can read more about here. Essentially, excitation with a 488nm laser causes rapid homodimerisation of the plasma membrane protein FGFR1. This causes calcium concentration to increase in the cell through IP3 release.
The left-most image is brightness, and is the amount of fluorescence. The central image is brightness, overlayed with the lifetime information.
The spike on the right hand side of the images is measuring the fluorescence lifetime (tau), and is an average of the entire image. You can see how average lifetime increases with calcium concentration. This sensor maxes out at around a lifetime of 3.5
We used whole field excitation to trigger calcium influx in all the cells, using a blue light laser.
What's really interesting to see is that even though all cells are exposed to the light at the same time, they clearly have different response times. You can also see some oscillating in the amount of calcium:

In these next two images, we used the same fluorescent molecule as above, but this time we only exposed a tiny area at the very edge of the cell to the laser. You can see a casade of response through the cell:

You'll notice a flash in the center of the cell below, before we fire the laser. We have no idea why it did that. Cells are living things, and this one felt like taking in a bunch of calcium on its own accord while we were imaging! Still, you can see the response to the laser so all good.

Other people's pictures
MCF-7 GREB1 PP7 - Transcription sites occur as bright areas in the cell. 1 frame/3 min. From Beckman 2021

Assembly of nuclear pores showing the 8 individual associated proteins, imaged using super resolution techniques. From Löschberger et al. 2012

You are not supposed to use your phone in the lab, don't be like me. (˶ᵔ ᵕ ᵔ˶)

I know this is overboard, look at how many culture flasks I have out waiting for me.. And that wasn't even all of them! I did not need to save all these cells. Ended up having BILLIONS but in my defence, my supervisor said to split the cells while she was on holidays, and she was nervous we didn't have enough.. i did not want to be the reason we wouldn't have enough.

Working in a microscopy lab means that you often spend the entire day in a windowless room with the lights off. Excess light from the room can interfere with the quality of the images you get, so it's always best to keep the room as dark as you can! I actually usually enjoy it because it's so cozy, and Big Light is my sworn enemy. However, this does mean that you get incredibly sleepy. I swear the department must run on pure caffeine.

This is just me being nostalgic for undergrad research. This lab was so full of STUFF and was incredibly chill. Look at my lab coat on the back of the chair, absolutely mopping the floor. A disgrace! I've only done projects in research institutes since then, and oh I long for the kicked back attitude of a university lab.. Or, my university lab, anyway.